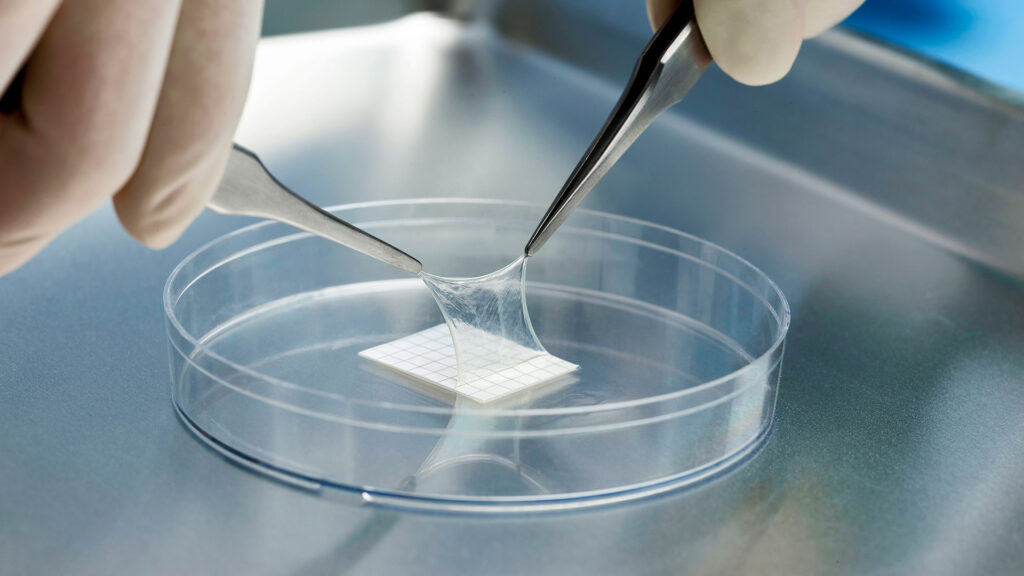
Amniotic Products Market Overview 2025 | Regional Overview, Analysis, and Future Outlook

Amniotic-Derived Products Overview:
The global amniotic products market is projected to expand at a compound annual growth rate (CAGR) of 8%, reaching approximately $1 billion by 2026. Key drivers of this growth include the rising number of amniotic membrane transplant procedures, increasing research in stem cell and regenerative medicine, growing awareness of the benefits of amniotic membrane transplantation, a higher incidence of traumatic wounds, and the expanding use of dehydrated amniotic membranes.
Download Sample Copy: https://meditechinsights.com/amniotic-products-market/request-sample/
Amniotic-derived products, including both amniotic membrane and amniotic fluid formulations, represent a class of orthobiologics increasingly recognized for their therapeutic potential in reducing joint inflammation and promoting tissue repair. The amniotic membrane (AM), or amnion, is a thin biological layer that surrounds the developing embryo or fetus and contains the amniotic fluid. According to the U.S. Food and Drug Administration (FDA), all products derived from amniotic, placental, and umbilical tissues are currently classified as human tissue products devoid of living cells.
Initially, amniotic membranes were used primarily in dermatology for the treatment of burns, ulcers, and other skin wounds. Over time, as their regenerative properties became better understood, AM and its derivatives found broader applications in medical fields such as ophthalmology, orthopedics, and neurosurgery. Today, they are used to treat corneal surface injuries, retinal detachments, limbal stem cell deficiencies, plantar fasciitis, ligament and tendon injuries, spinal disorders, cartilage repair, and osteoarthritis. Among the available types, cryopreserved and lyophilized amniotic membranes are the most widely used.
Competitive Landscape
Leading companies operating in the amniotic products market include MiMedx, Smith & Nephew, Organogenesis Inc., Integra LifeSciences, Applied Biologics, Katena Products Inc., Lucina BioSciences, Next Biosciences, Skye Biologics Holdings LLC, Surgenex LLC, Ventris Medical LLC, Vivex Biologics Inc., StimLabs LLC, Amniotics AB, LifeCell International Pvt. Ltd., NuVision Biotherapies Ltd., Genesis Biologics, Amnio Technology LLC, Amnicell Corporation Ltd., AlloSource, Celularity Inc., TissueTech Inc., Orthofix Medical Inc., Merakris Therapeutics, and Human Regenerative Technologies LLC, among others.
Rising Use of Amniotic-Based Products in Wound Healing
Amniotic membranes are composed of structural collagen, extracellular matrix components, and biologically active molecules that work synergistically to regulate the healing process. Chronic, non-healing wounds often remain in a prolonged inflammatory state, which disrupts the normal tissue repair cycle. This leads to reduced growth factor activity and an imbalance between protective and degradative enzymes—hindering the regeneration of healthy tissue.
Amniotic membranes can help restore this balance by supplying essential growth factors and cytokines that support cellular proliferation and tissue repair. In patients with diabetes or compromised immune systems—where the body’s natural wound-healing mechanisms are impaired—placental and amniotic-based therapies offer an effective alternative, promoting healing where conventional treatments often fail.
Expanding Role of Amniotic Membrane Products in Regenerative Medicine
Regenerative medicine, an interdisciplinary field focused on restoring or replacing damaged tissues and organs, is emerging as a major driver of amniotic membrane utilization. Amniotic membranes act as natural, biocompatible scaffolds and are rich sources of stem cells and growth factors, making them ideal for applications in tissue engineering and cell therapy.
Their high bioactivity and ability to entrap biomolecules also make them promising nano-reservoirs for drug delivery. The unique characteristics of amniotic membranes have enabled their use in diverse regenerative procedures—including tracheal reconstruction, diaphragm repair, bone and heart valve grafts, spinal cord regeneration, ophthalmologic treatments, osteoarthritis management, and even cosmetic applications such as dermal fillers for facial rejuvenation. As research advances, their role in regenerative therapies is expected to grow significantly.
“Amniotic-based products represent one of the most rapidly advancing areas in modern medicine. Breakthroughs in biomaterials, tissue engineering, and cellular biology are accelerating the development of novel therapies that could dramatically reduce disease burden.”
— Senior Director, Data Sciences & Quantitative Biology, U.S.-based Amniotic Products Company
Download Sample Copy: https://meditechinsights.com/amniotic-products-market/request-sample/
Regional Insights: North America at the Forefront
North America currently leads the global amniotic products market, followed by Europe. The region’s dominance is driven by strong research activity, advanced healthcare infrastructure, widespread adoption of amniotic membrane-based therapies, high awareness of amniotic transplantation benefits, and the presence of several key industry players.
Strategic Developments and Growth Initiatives
Market players are actively pursuing organic growth strategies—such as new product launches, R&D investments, and funding initiatives—to strengthen their market position.
- May 2022: MiMedx Group, Inc. received a $4.6 million grant from the U.S. Department of Defense to evaluate its PURION® processed Dehydrated Human Amnion Chorion Membrane (DHACM) for use in advanced wound and burn care.
- July 2021: Amniotics AB raised $6.1 million through its Nasdaq First North Growth Market listing to support preclinical development of mesenchymal stem cell (MSC)-based therapies derived from amniotic fluid.
- January 2021: Organogenesis Inc. obtained FDA approval to launch ReNu®, a cryopreserved amniotic suspension allograft designed to alleviate symptoms associated with knee osteoarthritis.
Browse Report: https://meditechinsights.com/amniotic-products-market/
About Medi-Tech Insights ;
Medi-Tech Insights is a healthcare-focused business research & insights firm. Our clients include Fortune 500 companies, blue-chip investors & hyper-growth start-ups. We have completed 100+ projects in Digital Health, Healthcare IT, Medical Technology, Medical Devices & Pharma Services in the areas of market assessments, due diligence, competitive intelligence, market sizing and forecasting, pricing analysis & go-to-market strategy. Our methodology includes rigorous secondary research combined with deep-dive interviews with industry-leading CXO, VPs, and key demand/supply side decision-makers.
Contact:
Ruta Halde
Associate, Medi-Tech Insights
+32 498 86 80 79